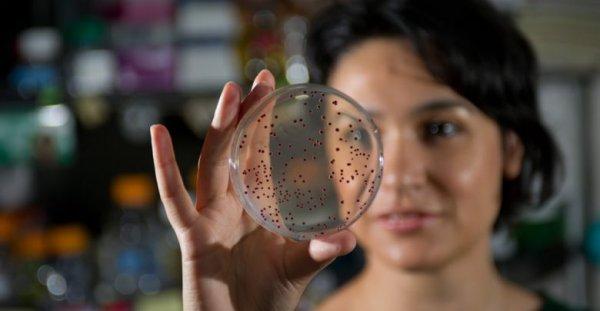
Betül Kaçar NASA ekibine kabul edildi

Astrobiyoloji alanında öğretim üyesi olan Betül Kaçar, sosyal medya hesabından yaptığı paylaşımla NASA’nın evrendeki yaşamın izlerini araştırmak için yeni kurulan ekibine kabul edildiğini duyurdu.
"İLAÇ GİBİ GELDİ"
Kaçar, şunları yazdı: “Güzel bir haber. Kelimelere dökmekte zorlanıyorum, ama şöyle: Evrende yaşamın izlerini araştırmak için oluşturulan yeni bir NASA ekibine kabul edilmişim. Bu seneye ufak bir sağlık sorunuyla başladım, ilaç gibi geldi bu haber sabah sabah. Her şeyin başı sağlık diyerek bitireyim.”

BETÜL KAÇAR KİMDİR?
19 yaşında Marmara Üniversitesi’nde öğrenci iken basvurduğu proje ile Amerikan Howard Hughes Tıp Enstitüsü'nde biyomoleküler kimya doktorasını tamamladı. 2012 yılında Harvard Üniversitesi’ne katılarak, Organizma ve Evrimsel Biyoloji Departmanı’nda görev aldı.
2017 yılında Arizona Üniversitesi’ne geçiş yaptı, burada da Moleküler ve Hücre Biyolojisi ve Astronomi alanında doçent olarak çalıştı. Kaçar’ın ayrıca Tokyo Teknoloji Enstitüsü Earth-Life Science Institute’ta da doçent unvanı bulunuyor.
Arizona Üniversitesi öğretim üyesi olan Kaçar, NASA’dan burs alan ilk Türkiye vatandaşı olmuştu.